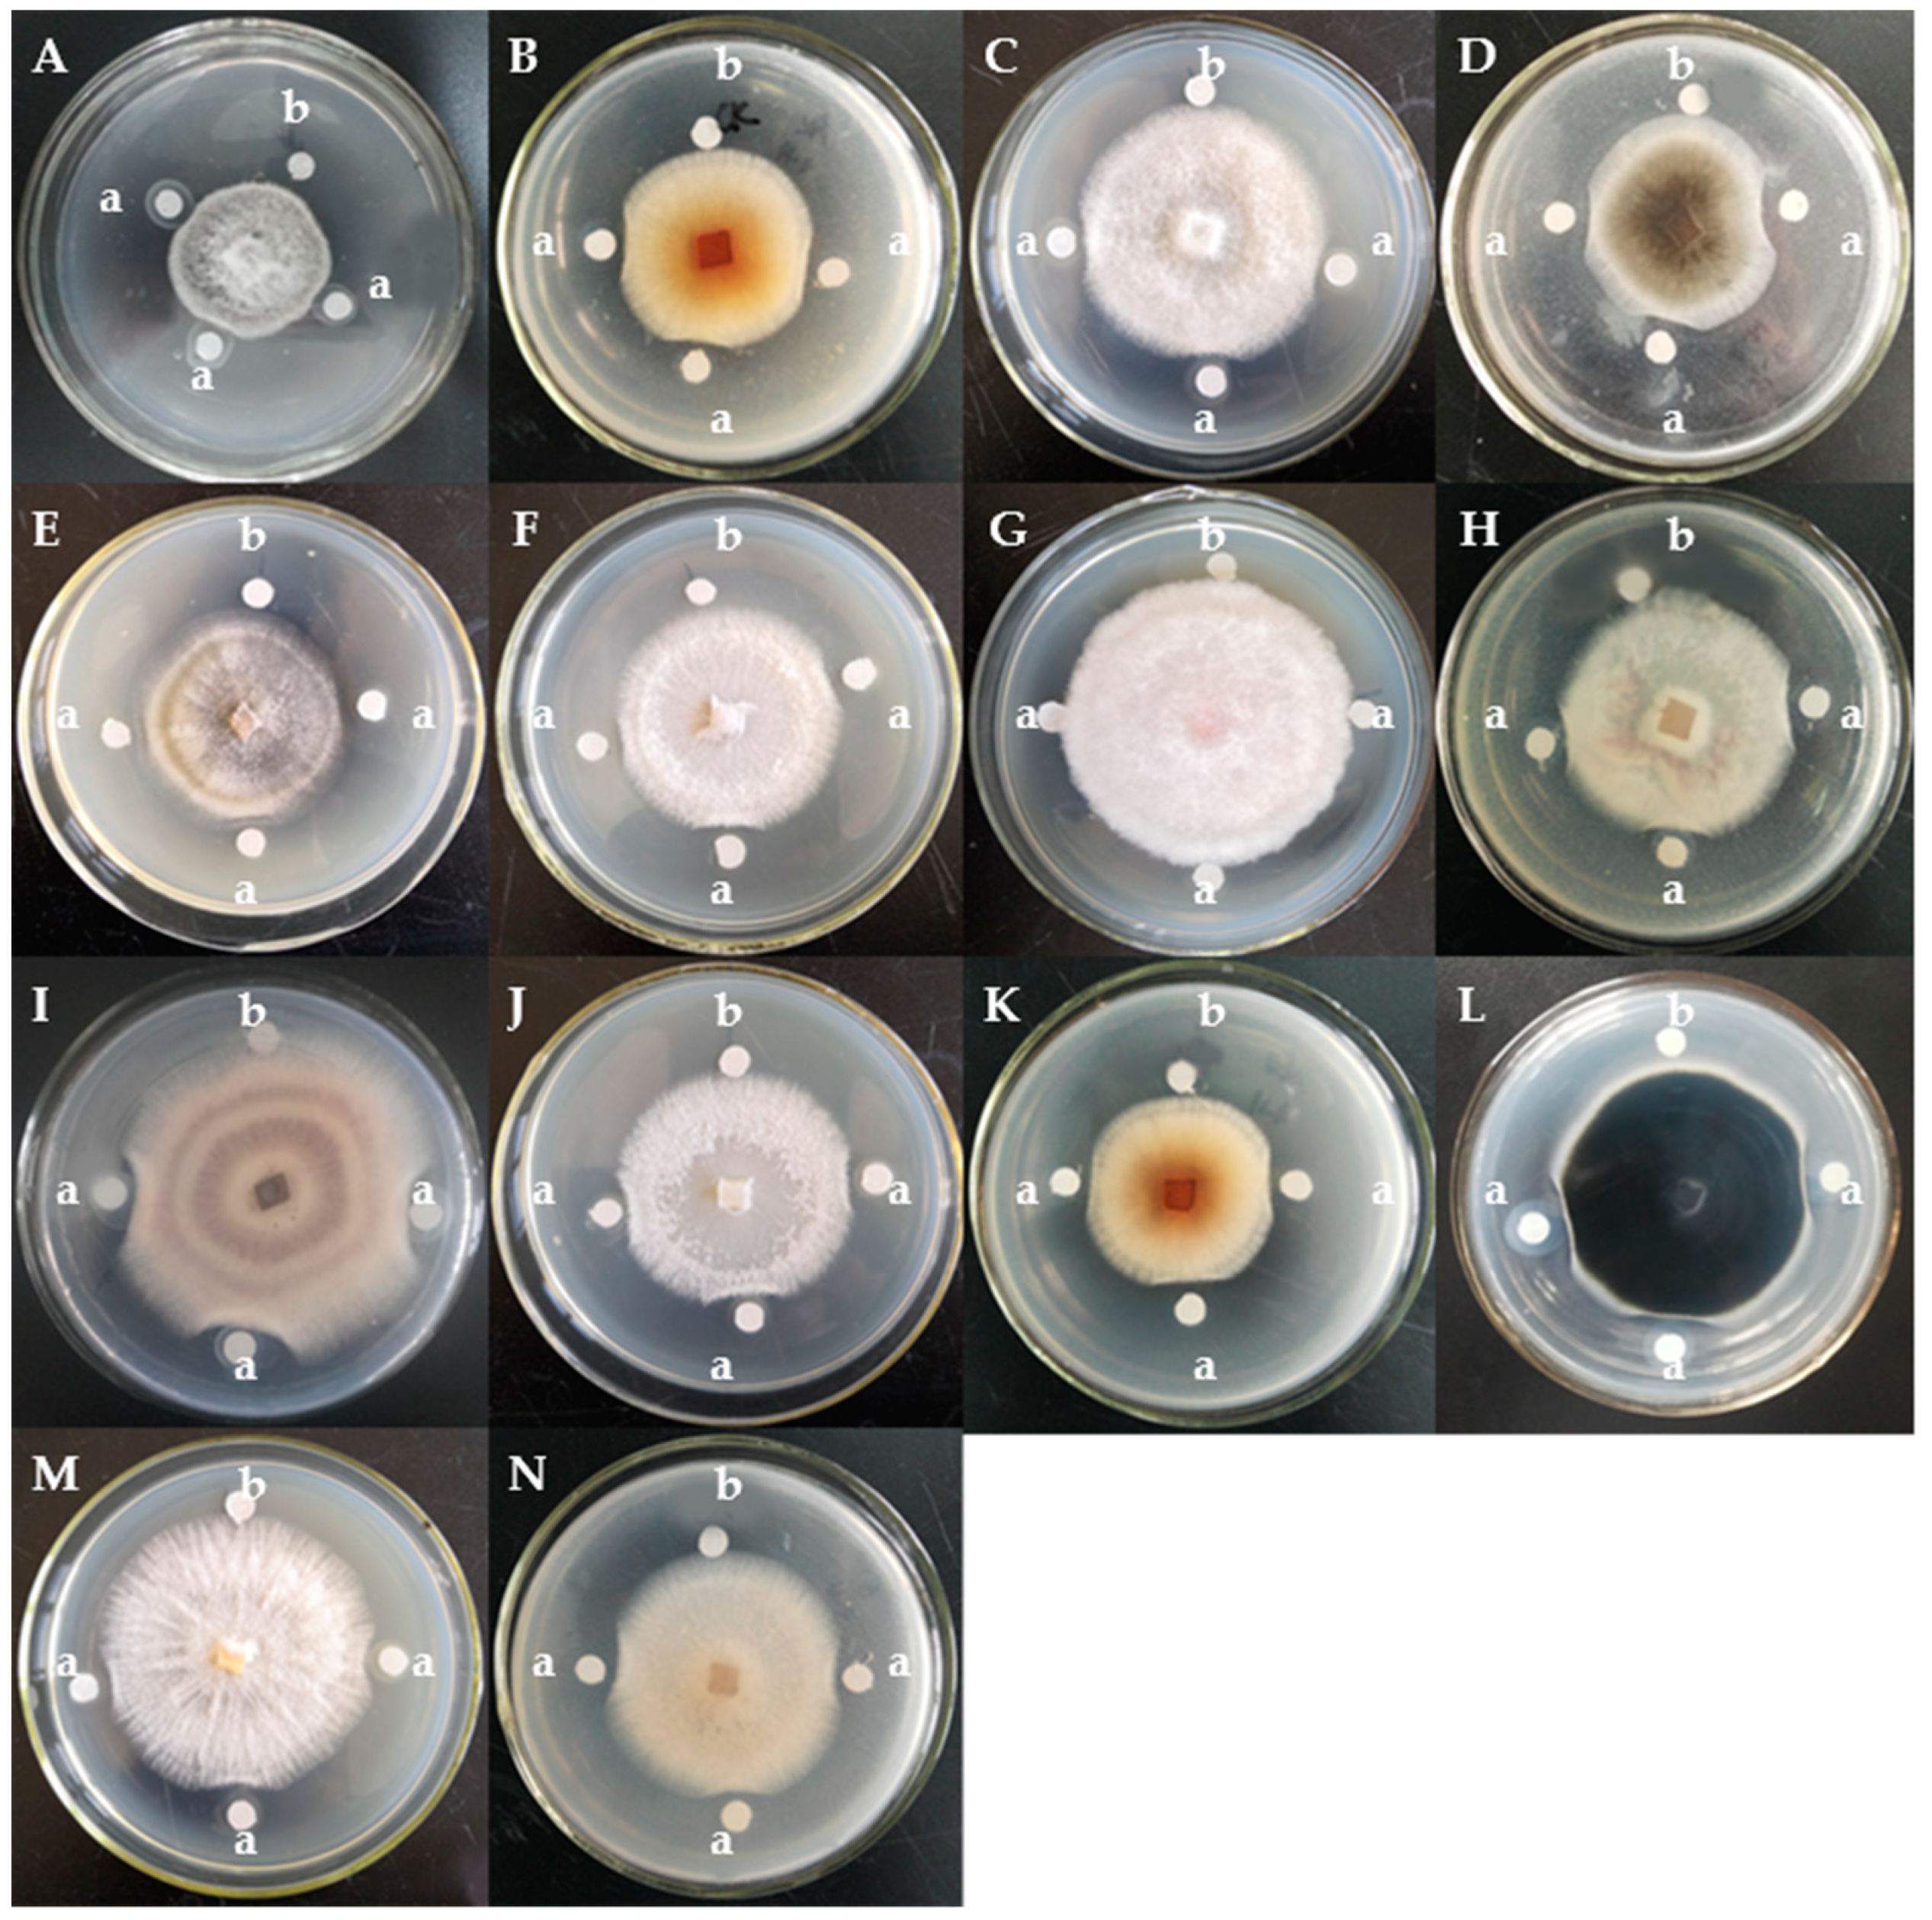
Molecules 24 01337 g002
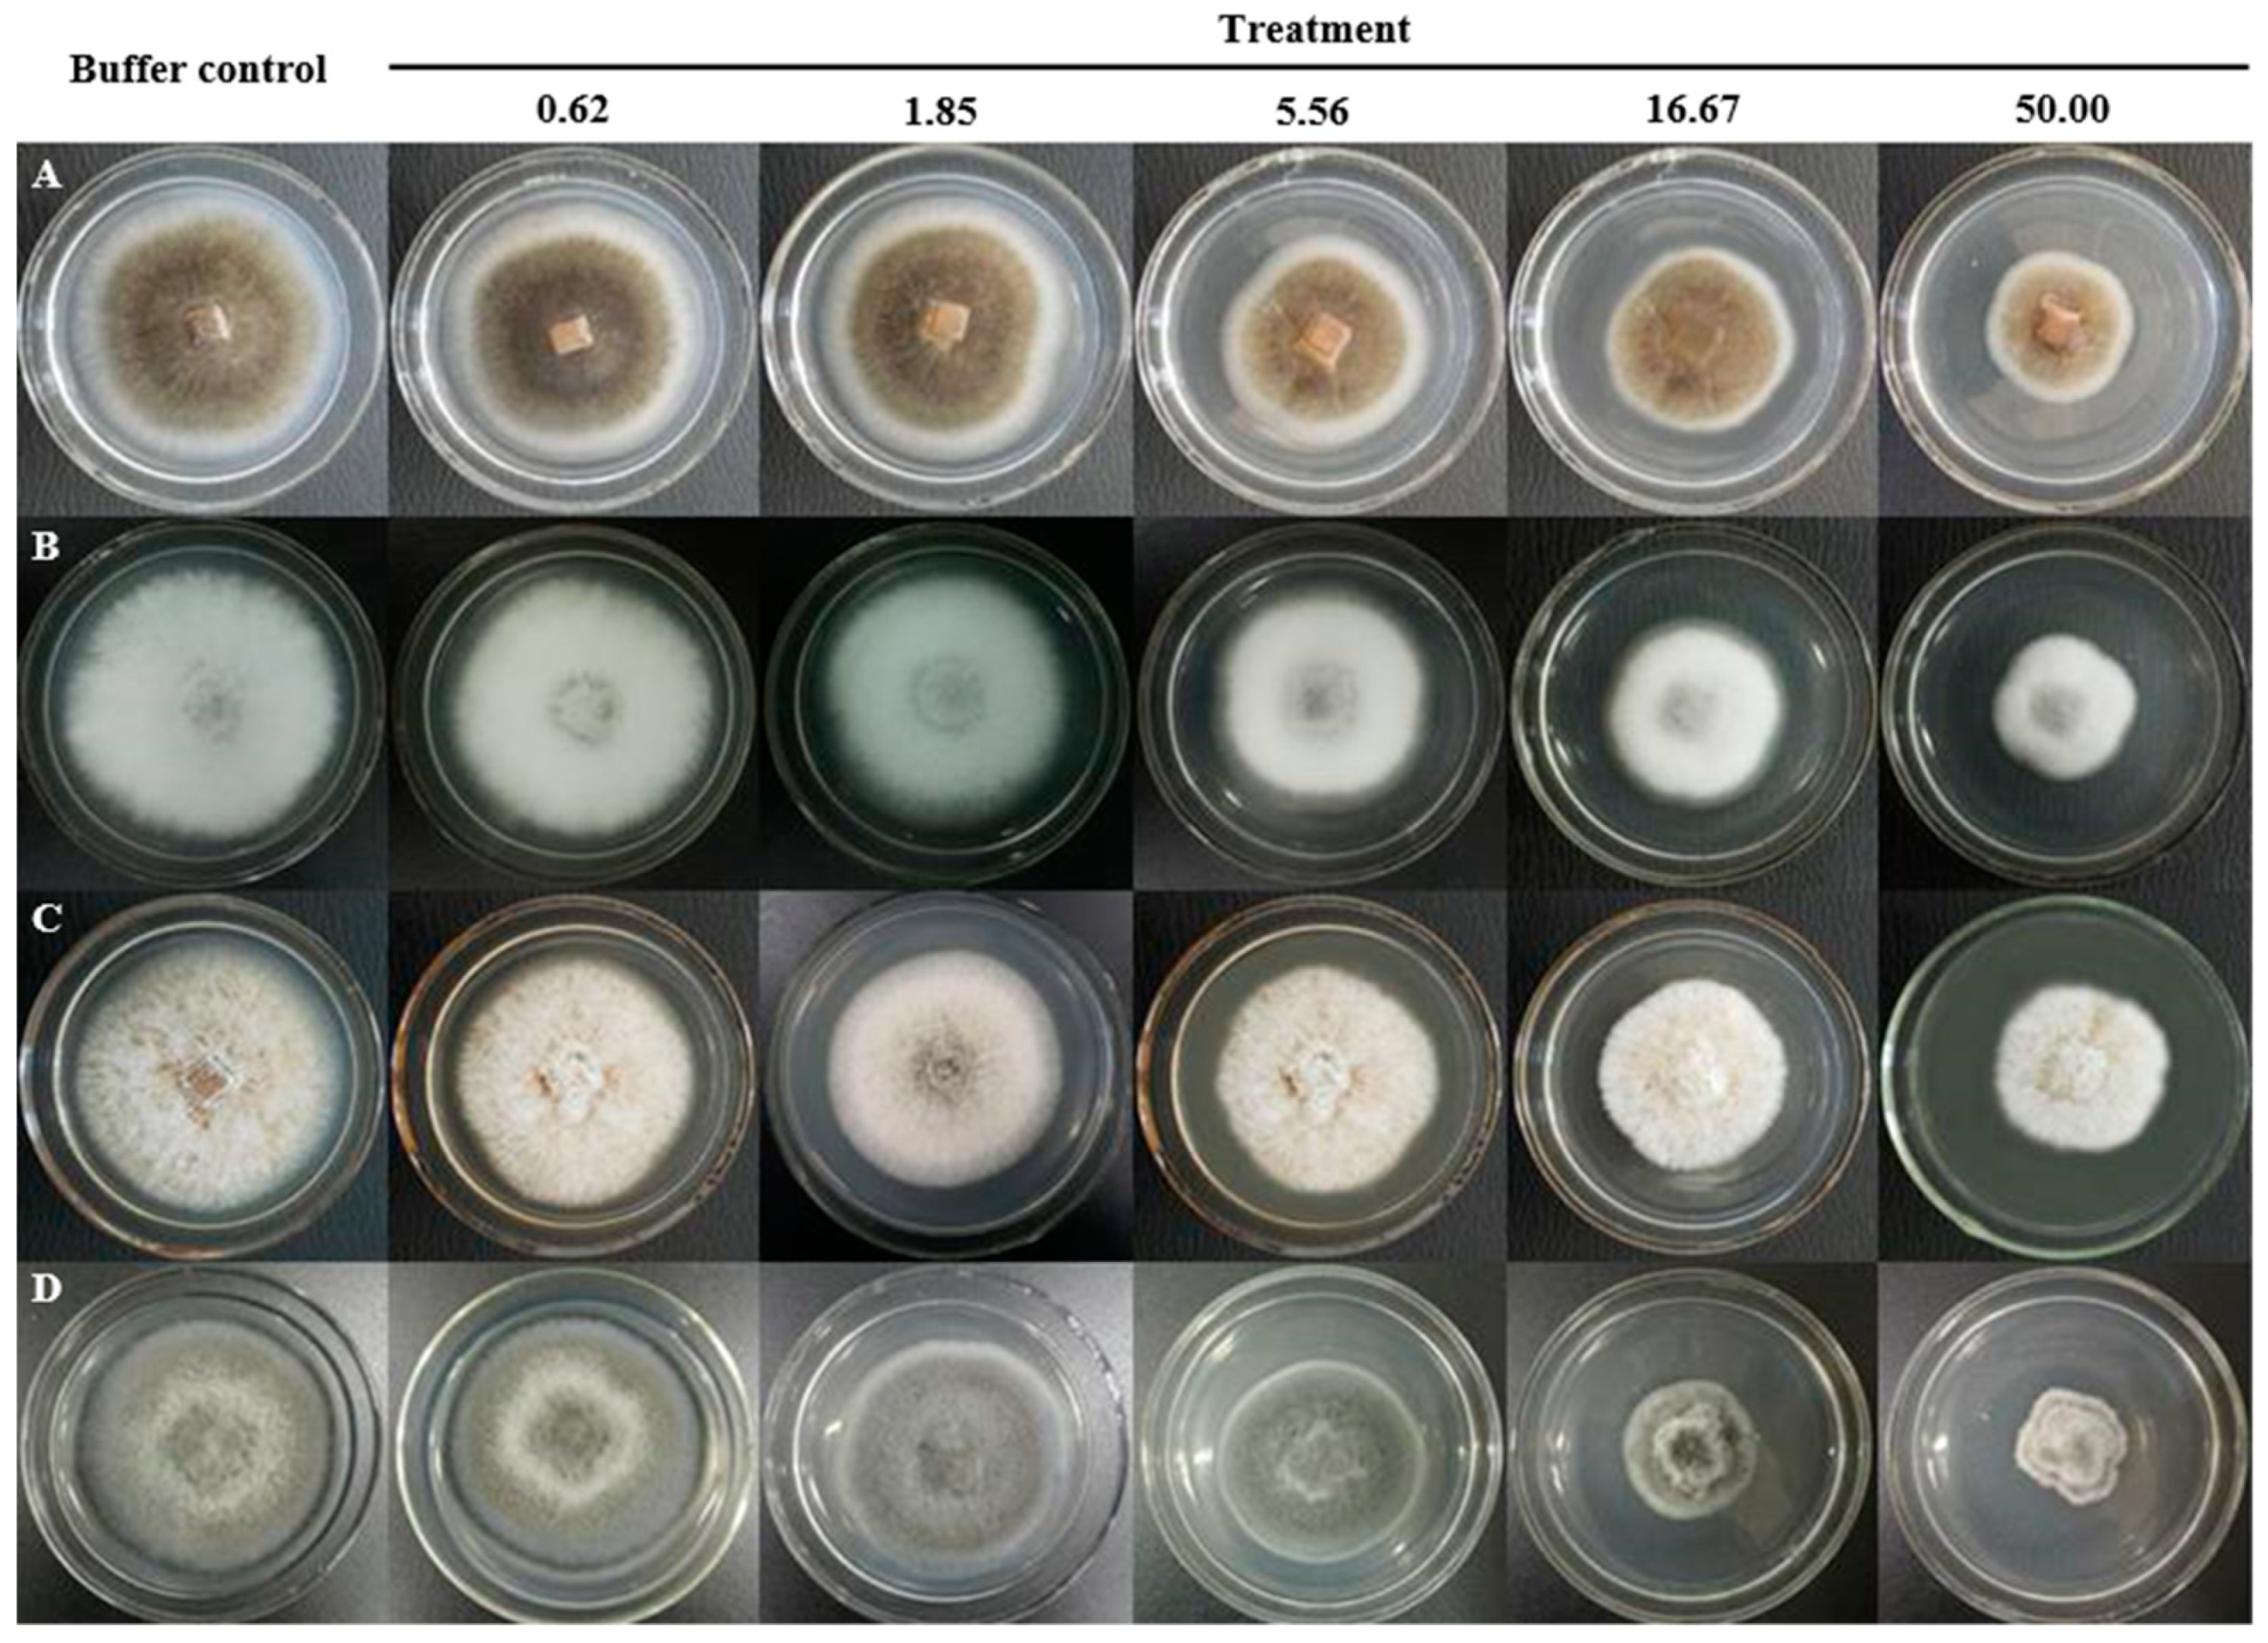
Molecules 24 01337 g003
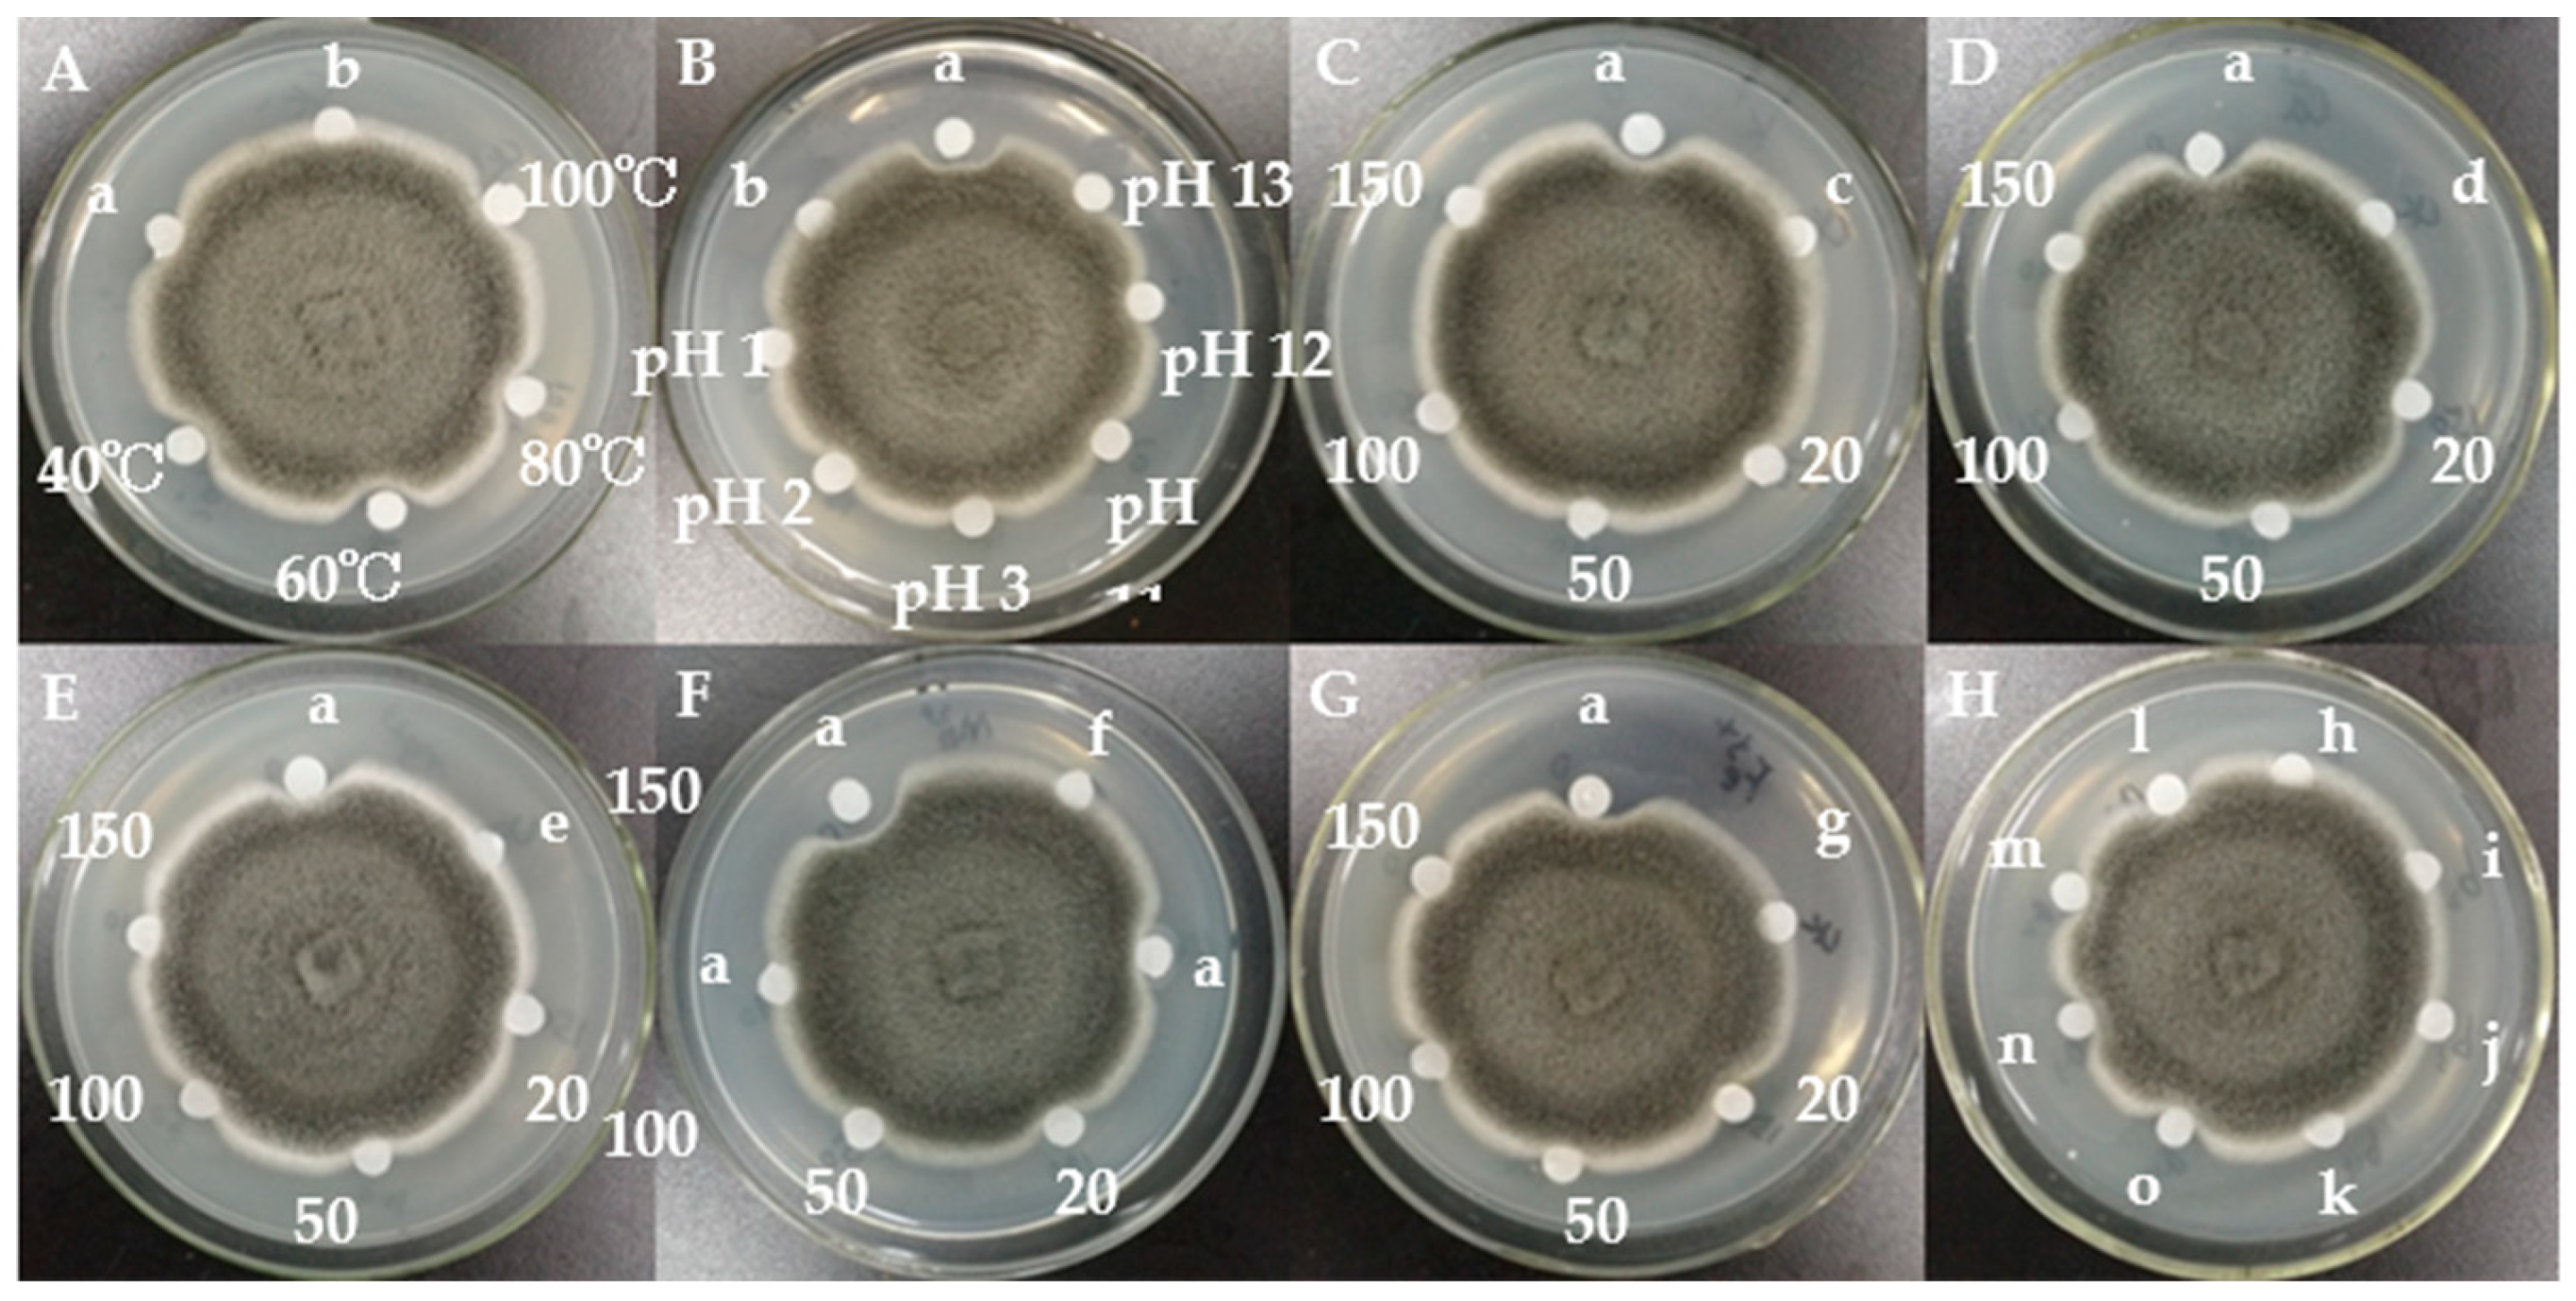
Molecules 24 01337 g004

Purification of an Antifungal Peptide from Seeds of Brassica oleracea var. gongylodes and Investigation of Its Antifungal Activity and Mechanism of Action
Abstract
1. Introduction
2. Results
3. Discussion
4. Materials and Methods
4.1. Materials
4.2. Purification of the Antifungal Peptide BGAP
4.3. Molecular Weight Determination by Tricine-SDS-PAGE, Mass Spectrometry and Determination of Concentration of Antifungal Peptide
4.4. Assay of Antifungal Activity
4.5. Assay of Antibacterial Activity
4.6. Assay of Stability of Antifungal Activity to Temperature Changes, pH Changes and in Presence of Metal Chlorides
4.7. Assay of Antifungal Activity Based on the Half-maximal Inhibitory Concentration
4.8. Assays of Cell Membrane Permeability Changes, Reactive Oxygen Species Production, Mitochondrial Membrane Potential Changes and Chitin Accumulation in the Fungus Mycosphaerella arachidicola
Author Contributions
Funding
Conflicts of Interest
References
- Fisher, M.C.; Henk, D.A.; Briggs, C.J.; Brownstein, J.S.; Madoff, L.C.; McCraw, S.L.; Gurr, S.J. Emerging fungal threats to animal, plant and ecosystem health. Nature 2012, 484, 186–194. [Google Scholar] [CrossRef] [PubMed]
- Godfray, H.C.J.; Mason-D’Croz, D.; Robinson, S. Food system consequences of a fungal disease epidemic in a major crop. Philos. Trans R. Soc. B Biol. Sci. 2016, 371. [Google Scholar] [CrossRef]
- Pitt, J.I.; Miller, J.D. A concise history of mycotoxin research. J. Agr. Food Chem. 2017, 65, 7021–7033. [Google Scholar] [CrossRef] [PubMed]
- Liew, W.P.P.; Mohd-Redzwan, S. Mycotoxin: its impact on gut health and microbiota. Front Cell Infect Microbiol. 2018, 8. [Google Scholar] [CrossRef]
- Hirooka, T.; Ishii, H. Chemical control of plant diseases. J. Gen. Plant Pathol. 2013, 79, 390–401. [Google Scholar] [CrossRef]
- He, D.C.; Zhan, J.S.; Xie, L.H. Problems, challenges and future of plant disease management: from an ecological point of view. J. Integr. Agr. 2016, 15, 705–715. [Google Scholar] [CrossRef]
- Hou, B.; Wu, L.H. Safety impact and farmer awareness of pesticide residues. Food Agr. Immunol. 2010, 21, 191–200. [Google Scholar] [CrossRef]
- Price, C.L.; Parker, J.E.; Warrilow, A.G.S.; Kelly, D.E.; Kelly, S.L. Azole fungicides-understanding resistance mechanisms in agricultural fungal pathogens. Pest Manag. Sci. 2015, 71, 1054–1058. [Google Scholar] [CrossRef] [PubMed]
- Meyer, V. A small protein that fights fungi: AFP as a new promising antifungal agent of biotechnological value. Appl. Microbiol. Biot. 2008, 78, 17–28. [Google Scholar] [CrossRef] [PubMed]
- Kaur, J.; Sagaram, U.S.; Shah, D. Can plant defensins be used to engineer durable commercially useful fungal resistance in crop plants? Fungal Biol. Rev. 2011, 25, 128–135. [Google Scholar] [CrossRef]
- Yan, J.; Yuan, S.S.; Jiang, L.L.; Ye, X.J.; Ng, T.B.; Wu, Z.J. Plant antifungal proteins and their applications in agriculture. Appl. Microbiol. Biot. 2015, 99, 4961–4981. [Google Scholar] [CrossRef] [PubMed]
- Leiter, E.; Gall, T.; Csernoch, L.; Pocsi, I. Biofungicide utilizations of antifungal proteins of filamentous ascomycetes: current and foreseeable future developments. Biocontrol 2017, 62, 125–138. [Google Scholar] [CrossRef]
- Lee, J.K.; Gopal, R.; Seo, C.H.; Cheong, H.; Park, Y. Isolation and purification of a novel deca-antifungal peptide from potato (Solanum tuberosum L. cv. Jopung) against Candida albicans. Int. J. Mol. Sci. 2012, 13, 4021–4032. [Google Scholar] [CrossRef] [PubMed]
- Ibrahim, M.; Kaushik, N.; Sowemimo, A.; Chhipa, H.; Koekemoer, T.; van de Venter, M.; Odukoya, O.A. Antifungal and antiproliferative activities of endophytic fungi isolated from the leaves of Markhamia tomentosa. Pharm. Biol. 2017, 55, 590–595. [Google Scholar] [CrossRef] [PubMed]
- Yan, H.; Yun, J.; Ai, D.; Zhang, W.; Bai, J.; Guo, J. Two novel cationic antifungal peptides isolated from Bacillus pumilus HN-10 and their inhibitory activity against Trichothecium roseum. World J. Microb. Biot. 2018, 34. [Google Scholar] [CrossRef]
- Mandal, S.M.; Migliolo, L.; Franco, O.L.; Ghosh, A.K. Identification of an antifungal peptide from Trapa natans fruits with inhibitory effects on Candida tropicalis biofilm formation. Peptides 2011, 32, 1741–1747. [Google Scholar] [CrossRef] [PubMed]
- Astafieva, A.A.; Rogozhin, E.A.; Andreev, Y.A.; Odintsova, T.I.; Kozlov, S.A.; Grishin, E.V.; Egorov, T.A. A novel cysteine-rich antifungal peptide ToAMP4 from Taraxacum officinale Wigg. flowers. Plant Physiol. Bioch. 2013, 70, 93–99. [Google Scholar] [CrossRef] [PubMed]
- Mandal, S.M.; Porto, W.F.; Dey, P.; Maiti, M.K.; Ghosh, A.K.; Franco, O.L. The attack of the phytopathogens and the trumpet solo: identification of a novel plant antifungal peptide with distinct fold and disulfide bond pattern. Biochimie 2013, 95, 1939–1948. [Google Scholar] [CrossRef] [PubMed]
- Oddepally, R.; Guruprasad, L. Isolation, purification, and characterization of a stable defensin-like antifungal peptide from Trigonella foenum-graecum (fenugreek) seeds. Biochemistry 2015, 80, 332–342. [Google Scholar] [CrossRef] [PubMed]
- Rogozhin, E.A.; Slezina, M.P.; Slavokhotova, A.A.; Istomina, E.A.; Korostyleva, T.V.; Smirnov, A.N.; Grishin, E.V.; Egorov, T.A.; Odintsova, T.I. A novel antifungal peptide from leaves of the weed Stellaria media L. Biochimie 2015, 116, 125–132. [Google Scholar] [CrossRef]
- Yin, C.; Wong, J.H.; Ng, T.B. Isolation of a hemagglutinin with potent antiproliferative activity and a large antifungal defensin from Phaseolus vulgaris cv. hokkaido large pinto beans. J. Agr. Food Chem. 2015, 63, 5439–5448. [Google Scholar] [CrossRef] [PubMed]
- Lam, S.K.; Ng, T.B. Purification and characterization of an antifungal peptide with potent antifungal activity but devoid of antiproliferative and HIV reverse transcriptase activities from legumi secchi beans. Appl. Biochem. Biotech. 2013, 169, 2165–2174. [Google Scholar] [CrossRef]
- Wang, S.Y.; Rao, P.F.; Ye, X.Y. Isolation and biochemical characterization of a novel leguminous defense peptide with antifungal and antiproliferative potency. Appl. Microbiol. Biot. 2009, 82, 79–86. [Google Scholar] [CrossRef] [PubMed]
- Vasilchenko, A.S.; Smirnov, A.N.; Zavriev, S.K.; Grishin, E.V.; Vasilchenko, A.V.; Rogozhin, E.A. Novel thionins from black seed (Nigella sativa L.) demonstrate antimicrobial activity. Int. J. Pept. Res. Ther. 2017, 23, 171–180. [Google Scholar] [CrossRef]
- Taveira, G.B.; Mathias, L.S.; da Motta, O.V.; Machado, O.L.T.; Rodrigues, R.; Carvalho, A.O.; Teixeira-Ferreira, A.; Perales, J.; Vasconcelos, I.M.; Gomes, V.M. Thionin-like peptides from Capsicum annuum fruits with high activity against human pathogenic bacteria and yeasts. Biopolymers 2014, 102, 30–39. [Google Scholar] [CrossRef] [PubMed]
- Franco, O.L.; Murad, A.M.; Leite, J.R.; Mendes, P.A.M.; Prates, M.V.; Bloch, C. Identification of a cowpea gamma-thionin with bactericidal activity. Febs J. 2006, 273, 3489–3497. [Google Scholar] [CrossRef] [PubMed]
- Fujimura, M.; Ideguchi, M.; Minami, Y.; Watanabe, K.; Tadera, K. Purification, characterization, and sequencing of novel antimicrobial peptides, Tu-AMP 1 and Tu-AMP 2, from bulbs of tulip (Tulipa gesneriana L.). Biosci. Biotech. Bioch. 2004, 68, 571–577. [Google Scholar] [CrossRef]
- De Lucca, A.J.; Cleveland, T.E.; Wedge, D.E. Plant-derived antifungal proteins and peptides. Can. J. Microbiol. 2005, 51, 1001–1014. [Google Scholar] [CrossRef]
- Van der Weerden, N.L.; Bleackley, M.R.; Anderson, M.A. Properties and mechanisms of action of naturally occurring antifungal peptides. Cell Mol. Life Sci. 2013, 70, 3545–3570. [Google Scholar] [CrossRef]
- Ye, X.; Ng, T.B. Isolation and characterization of juncin, an antifungal protein from seeds of japanese takana (Brassica juncea var. integrifolia). J. Agr. Food Chem. 2009, 57, 4366–4371. [Google Scholar] [CrossRef]
- Lin, P.; Ng, T.B. Brassiparin, an antifungal peptide from Brassica parachinensis seeds. J. Appl. Microbiol. 2009, 106, 554–563. [Google Scholar] [CrossRef]
- Lin, P.; Ng, T.B. A novel and exploitable antifungal peptide from kale (Brassica alboglabra) seeds. Peptides 2008, 29, 1664–1671. [Google Scholar] [CrossRef]
- Lin, P.; Wong, J.H.; Xia, L.; Ng, T.B. Campesin, a thermostable antifungal peptide with highly potent antipathogenic activities. J. Biosci. Bioeng. 2009, 108, 259–265. [Google Scholar] [CrossRef]
- Lin, P.; Xia, L.; Wong, J.H.; Ng, T.B.; Ye, X.; Wang, S.; Shi, X. Lipid transfer proteins from Brassica campestris and mung bean surpass mung bean chitinase in exploitability. J. Pept. Sci. 2007, 13, 642–648. [Google Scholar] [CrossRef]
- Thevissen, K.; Osborn, R.W.; Acland, D.P.; Broekaert, W.F. Specific, high affinity binding sites for an antifungal plant defensin on Neurospora crassa hyphae and microsomal membranes. J. Biol. Chem. 1997, 272, 32176–32181. [Google Scholar] [CrossRef]
- Thevissen, K.; Warnecke, D.C.; Francois, E.J.A.; Leipelt, M.; Heinz, E.; Ott, C.; Zahringer, U.; Thomma, B.P.H.J.; Ferkel, K.K.A.; Cammue, B.P.A. Defensins from insects and plants interact with fungal glucosylceramides. J. Biol. Chem. 2004, 279, 3900–3905. [Google Scholar] [CrossRef]
- Cools, T.L.; Vriens, K.; Struyfs, C.; Verbandt, S.; Ramada, M.H.S.; Brand, G.D.; Bloch, C.; Koch, B.; Traven, A.; Drijfhout, J.W.; et al. The Antifungal plant defensin HsAFP1 is a phosphatidic acid-interacting peptide inducing membrane permeabilization. Front Microbiol. 2017, 8. [Google Scholar] [CrossRef]
- Palffy, R.; Gardlik, R.; Behuliak, M.; Kadasi, L.; Turna, J.; Celec, P. On the physiology and pathophysiology of antimicrobial peptides. Mol. Med. 2009, 15, 51–59. [Google Scholar]
- Aerts, A.M.; Bammens, L.; Govaert, G.; Carmona-Gutierrez, D.; Madeo, F.; Cammue, B.P.A.; Thevissen, K. The antifungal plant defensin HsAFP1 from Heuchera sanguinea induces apoptosis in Candida albicans. Front Microbiol. 2011, 2. [Google Scholar] [CrossRef]
- Krysko, D.V.; Roels, F.; Leybaert, L.; D’Herde, K. Mitochondrial transmembrane potential changes support the concept of mitochondrial heterogeneity during apoptosis. J. Histochem. Cytochem. 2001, 49, 1277–1284. [Google Scholar] [CrossRef]
- Circu, M.L.; Aw, T.Y. Reactive oxygen species, cellular redox systems, and apoptosis. Free Radical Bio. Med. 2010, 48, 749–762. [Google Scholar] [CrossRef] [PubMed]
- Savitskaya, M.A.; Onishchenko, G.E. Mechanisms of apoptosis. Biochemistry 2015, 80, 1393–1405. [Google Scholar] [CrossRef]
- Fang, E.F.; Hassanien, A.A.E.; Wong, J.H.; Bah, C.S.F.; Soliman, S.S.; Ng, T.B. Purification and modes of antifungal action by Vicia faba cv. egypt trypsin inhibitor. J. Agr. Food Chem. 2010, 58, 10729–10735. [Google Scholar] [CrossRef] [PubMed]
- Lam, S.K.; Ng, T.B. First report of an antifungal amidase from Peltophorum ptercoarpum. Biomed. Chromatogr. 2010, 24, 458–464. [Google Scholar] [CrossRef] [PubMed]
- Ye, X.J.; Ng, T.B.; Wu, Z.J.; Xie, L.H.; Fang, E.F.; Wong, J.H.; Pan, W.L.; Wing, S.S.C.; Zhang, Y.B. Protein from red cabbage (Brassica oleracea) seeds with antifungal, antibacterial, and anticancer activities. J. Agr. Food Chem. 2011, 59, 10232–10238. [Google Scholar] [CrossRef] [PubMed]
- Delgado, J.; Owens, R.A.; Doyle, S.; Asensio, M.A.; Nunez, F. Increased chitin biosynthesis contributes to the resistance of Penicillium polonicum against the antifungal protein PgAFP. Appl. Microbiol. Biot. 2016, 100, 371–383. [Google Scholar] [CrossRef]
- Schagger, H. Tricine-SDS-PAGE. Nat. Protoc. 2006, 1, 16–22. [Google Scholar] [CrossRef]
- Brambila Vieira, M.E.; Vasconcelos, I.M.; Tavares Machado, O.L.; Gomes, V.M.; Carvalho, A.D.O. Isolation, characterization and mechanism of action of an antimicrobial peptide from Lecythis pisonis seeds with inhibitory activity against Candida albicans. Acta Bioch. Bioph. Sin. 2015, 47, 716–729. [Google Scholar] [CrossRef]
- Ghosh, P.; Roy, A.; Hess, D.; Ghosh, A.; Das, S. Deciphering the mode of action of a mutant Allium sativum leaf agglutinin (mASAL), a potent antifungal protein on Rhizoctonia solani. Bmc Microbiol. 2015, 15. [Google Scholar] [CrossRef]
- Wong, J.H.; Lau, K.M.; Wu, Y.O.; Cheng, L.; Wong, C.W.; Yew, D.T.W.; Leung, P.C.; Fung, K.P.; Hui, M.; Ng, T.B.; et al. Antifungal mode of action of macrocarpal C extracted from Eucalyptus globulus Labill (Lan An) towards the dermatophyte Trichophyton mentagrophytes. Chin. Med. 2015, 10. [Google Scholar] [CrossRef]
Sample Availability: Samples of the compounds are not available from the authors. |

| Protein/Peptide | Accession No. | Species of Origin | Mol wt | Sequence | Protein Score | Protein Score C.I. % |
|---|---|---|---|---|---|---|
| defensin-like protein 1 | XP_013619391.1 | Brassica oleracea var. oleracea | 8694.2 Da | MAKFASIIALLFAALVLFAALEAPTMVEAQKLCERPSGTWSGVCGNNNACKNQCINLEKARHGSCNYVFPAHKCICYFPC | 112 | 100 |
| thionin | BAM15659.1 | Brassica oleracea var. viridis | 7194.5 Da | VALLFSALVIFAAFEAPTMVEAQKLCERPSGTWSGVCGNNNACKNQCIRLEKARHGSCNYVFPAHK | 89 | 99.99 |
| defensin-like protein 1 | XP_013590720.1 | Brassica oleracea var. oleracea | 8784.3 Da | MAKFASIIVLLFAALVLFAGFEAPTMVEAQKLCERPSGTWSGVCGNNNACKNQCIRLEKARHGSCNYVFPAHKCICYFPC | 88 | 99.99 |
| thionin | BAM15658.1 | Brassica oleracea var. viridis | 6328.1 Da | IVLLFAEAPTMVEAQKLCERPSGTWSGVCGNNNGCKNQGIRLEKARHGSCNYVFPAHK | 83 | 99.97 |
| defensin-like protein 3 | XP_013590858.1 | Brassica oleracea var. oleracea | 8619.1 Da | MAKAATITTFLFAALVLFAAFEAPTMVDAKLCERPSGTWSGVCGNNNECKKQCIRLEGARHGSCNYVFPAHKCICYFPC | 82 | 99.97 |
| defensin-like protein 4 | XP_013635185.1 | Brassica oleracea var. oleracea | 10573.2 Da | MDKATKSVSSLAAFFILFLVIFEMPEIEAQDSECLKEYGGDVGFGFCAPRIYPTFCVKRCRADKGALGGKCIWGQGSNVKCLCNFCRPEPGQILSGI | 77 | 99.88 |
| defensin-like protein 195 | XP_013634959.1 | Brassica oleracea var. oleracea | 9897.7 Da | MAIKPLSIFVVFFIFFLVISDMPETEAQDSKCLREYGGDVGFGFCAPRIFPTICYTRCRENKGAKGGRCRWGQGTNVTCLCDYCNDQP | 66 | 98.36 |
| Type | Peptide | Species of Origin | Antimicrobial Activity Toward Fungi or Bacteria | Ref. |
|---|---|---|---|---|
| BGAP | Brassica oleracea var. gongylodes | Fungi:Colletotrichum higginsianum (17.33 μg/mLa), Exserohilum turcicum (12.37 μg/mLa), Magnaporthe oryzae (16.81 μg/mLa), Mycosphaerella arachidicola (5.60 μg/mLa), etc. | This study | |
| Defensin-like peptide | Tf-AFP | Trigonella foenum-graecum | Fungi:Fusarium oxysporum, Fusarium solani, Rhizoctonia solani | [19] |
| Large pinto bean defensin | Phaseolus vulgaris | Fungi:Bipolaris maydis, Fusarium oxysporum, Mycosphaerella arachidicola, Setosphaeria turcica, Valsa mali (no effect) | [21] | |
| Legumi secchi peptide | Phaseolus vulgaris | Fungi:Fusarium oxysporum (9.2 μMa), Helminthosporium maydis (9.5 μMa), Mycosphaerella arachidicola (1 μMa), Rhizoctonia solani (3.5 μMa), Valsa mali (no effect) | [22] | |
| Limyin | Phaseolus limensis | Fungi:Alternaria alternata, Botrytis cinerea, Fusarium solani (8.6 μMa), Mycosphaerella arachidicola (no effect), Pythium aphanidermatum (no effect) Bacteria: Staphylococcus aureus (no effect), Salmonella sp. (no effect) | [23] | |
| Thionin-like peptide | NsW2 | Nigella sativa | Fungi:Candida albicans (1.63 μMa) Bacteria: Bacillus subtilis (1.63 μMa), Escherichia coli (>26.0 μMa), Staphylococcus aureus (3.25 μMa) | [24] |
| Capsicum annuum peptide | Capsicum annuum | Fungi:Candida albicans (96%b, 100 μg/mLc), Candida tropicalis (100%b, 100 μg/mLc), Saccharomyces cerevisiae (98%b, 100 μg/mLc) Bacteria: Escherichia coli (18%b, 100 μg/mLc), Pseudomonas aeruginosa (10%b, 100 μg/mLc) | [25] | |
| Cp-thionin II | Vigna unguiculata | Bacteria:Escherichia coli (64 μg/mLd), Pseudomonas syringae (42 μg/mLd), Staphylococcus aureus (128 μg/mLd), Erwinia sp. (no effect), Ralstonia solanacearum (no effect); Rhataybacter sp. (no effect) | [26] | |
| Tu-AMP 1 | Tulipa gesneriana | Fungi:Fusarium oxysporum (2 μg/mLa), Geotrichum candidum (2 μg/mLa); Agrobacterium radiobacter (15 μg/mLa) Bacteria: Agrobacterium rhizogenes (20 μg/mLa), Curtobacterium flaccumfaciens (13 μg/mLa), Clavibacter michiganensis (14 μg/mLa), Erwinia carotovora (11 μg/mLa) | [27] |
| Protein/Peptide | Species of Origin | Mol (wt) | Antifungal Activity | Stability | Reported Effect | Ref. |
|---|---|---|---|---|---|---|
| BGAP | Brassica oleracea var. gongylodes | 8.5 kDa | Colletotrichum higginsianum (16.94 μg/mL), Exserohilum turcicum (12.30 μg/mL), Magnaporthe oryzae (16.45 μg/mL), Mycosphaerella arachidicola (5.70 μg/mL), etc. | 40–100 °C; pH 1–3, pH 11–13; methanol, ethanol, isopropanol, chloroform (10%); Ca2+, Fe3+, K+, Mg2+ (20–150 mM) | Accumulation of chitin at the tip of mycelium, membrane permeabilization, change of mitochondrial membrane potential, ROS generation | This study |
| Juncin | Brassica juncea var. integrifolia | 18.9 kDa | Fusarium oxysporum (13.5 μM), Helminthosporium maydis (27 μM), Mycosphaerella arachidicola (10 μM), Candida albicans | Not tested | No membrane permeabilization (toward Candida albicans) and chitin deposition (toward Mycosphaerella arachidicola) | [30] |
| Brassiparin | 5716 kDa | Brassica parachinensis | Fusarium oxysporum (3.9 μM), Helminthosporium maydis (4.7 μM), Mycosphaerella arachidicola (2.6 μM), Valsa mali (0.22 μM) | 40–100 °C; pH 1–3, pH 11–13 | Not tested | [31] |
| Kale peptide | Brassica alboglabra | 5907 Da | Fusarium oxysporum (4.3 μM), Helminthosporium maydis (2.1 μM), Mycosphaerella arachidicola (2.4 μM), Valsa mali (0.15 μM) | 20–80 °C; pH 2–3, pH 10–11 | Not tested | [32] |
| Campesin | Brassica campestris | 9.4 kDa | Fusarium oxysporum (5.1 μM), Mycosphaerella arachidicola (4.4 μM) | 0–100 °C; pH 0–14 | Not tested | [33] |
| nsLTP | Brassica campestris | 9414 Da | Fusarium oxysporum (8.3 μM), Helminthosporium staivum, Mycosphaerella arachidicola (4.5 μM), Sclerotinia sclerotiorum, Verticivium albotarum | 20–100 °C; pH 0–4, pH 9–14 | Not tested | [34] |
© 2019 by the authors. Licensee MDPI, Basel, Switzerland. This article is an open access article distributed under the terms and conditions of the Creative Commons Attribution (CC BY) license (http://creativecommons.org/licenses/by/4.0/).
Share and Cite
Wang, C.; Zhang, Y.; Zhang, W.; Yuan, S.; Ng, T.; Ye, X. Purification of an Antifungal Peptide from Seeds of Brassica oleracea var. gongylodes and Investigation of Its Antifungal Activity and Mechanism of Action. Molecules 2019, 24, 1337. https://doi.org/10.3390/molecules24071337
Wang C, Zhang Y, Zhang W, Yuan S, Ng T, Ye X. Purification of an Antifungal Peptide from Seeds of Brassica oleracea var. gongylodes and Investigation of Its Antifungal Activity and Mechanism of Action. Molecules. 2019; 24(7):1337. https://doi.org/10.3390/molecules24071337
Chicago/Turabian StyleWang, Caicheng, Yao Zhang, Weiwei Zhang, Susu Yuan, Tzibun Ng, and Xiujuan Ye. 2019. "Purification of an Antifungal Peptide from Seeds of Brassica oleracea var. gongylodes and Investigation of Its Antifungal Activity and Mechanism of Action" Molecules 24, no. 7: 1337. https://doi.org/10.3390/molecules24071337
APA StyleWang, C., Zhang, Y., Zhang, W., Yuan, S., Ng, T., & Ye, X. (2019). Purification of an Antifungal Peptide from Seeds of Brassica oleracea var. gongylodes and Investigation of Its Antifungal Activity and Mechanism of Action. Molecules, 24(7), 1337. https://doi.org/10.3390/molecules24071337
